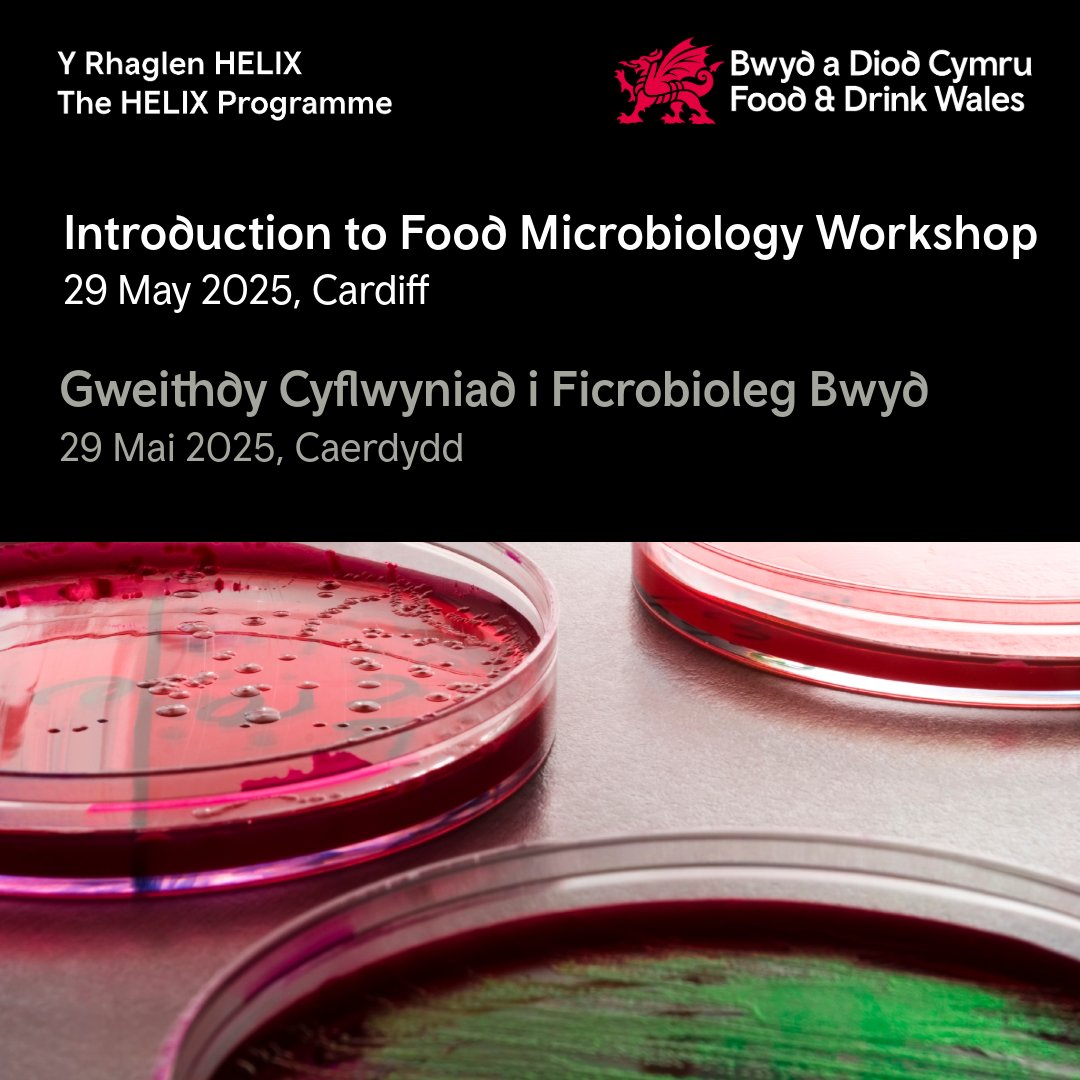

Canolfan Diwydiant Bwyd ZERO2FIVE
@zero2five_cym
Mae ZERO2FIVE yn darparu cymorth technegol, gweithredol a masnachol i gwmnïoedd bwyd a diod. Wedi ein lleoli @MetCaerdydd ac yn rhan o @ArloesiBwyd
ID: 975755511609090048
http://www.zero2five.org.uk 19-03-2018 15:26:57
1,1K Tweet
72 Followers
41 Following




Buom yn gweithio gyda Fablas Icecream i ddadansoddi eu prosesau cynhyrchu yn fanwl a chynnal archwiliad gwastraff. Fe wnaethom adolygu llinellau allweddol, gan helpu i nodi gor-gynhyrchu, a chefnogi’r cwmni i adeiladu offeryn castio cynnyrch hawdd ei ddefnyddio.